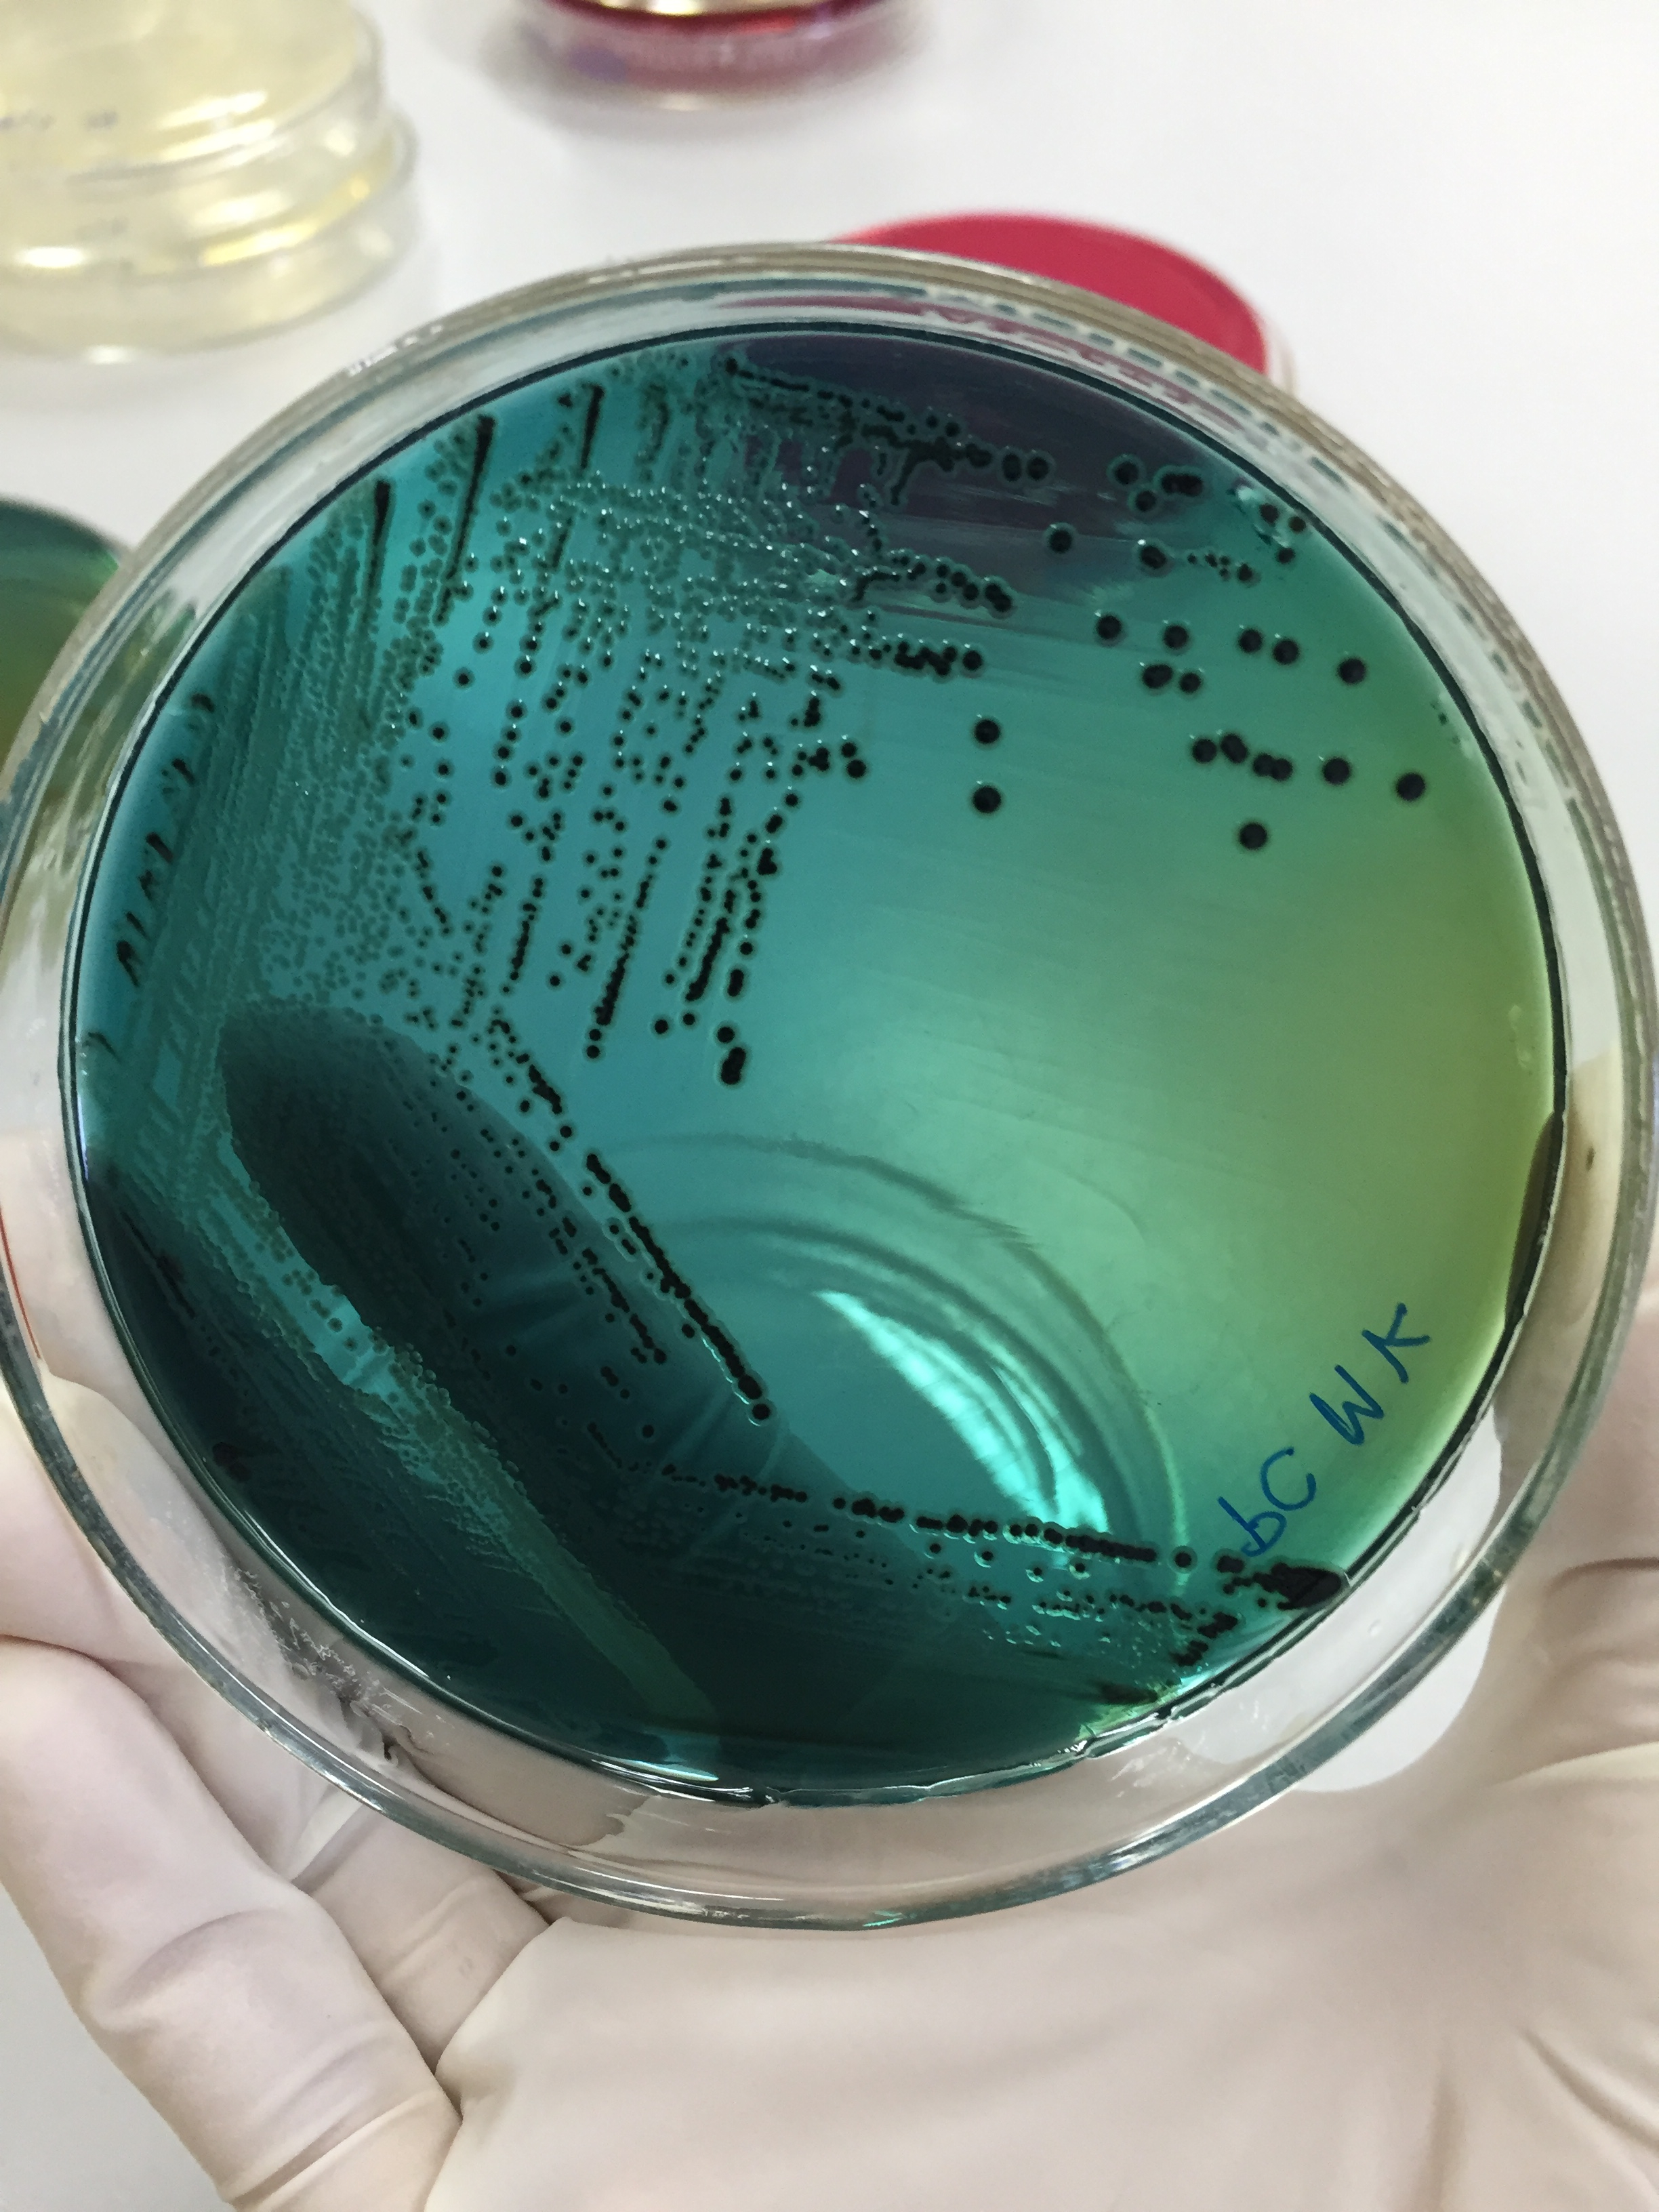

Why is bacterial contamination so dangerous and who is at greatest risk?
What specific steps can you take to mitigate against the risk of bacterial contamination?
Lear about the hidden danger of eggs and what you should and shouldn't do.
Learn Vital Information About Bacterial Contamination and the Steps to Prevent it.
In 'Bacterial Contamination Kills,' you'll gain valuable insights into the risks of bacterial contamination and acquire the knowledge to prevent it. This comprehensive resource equips food handlers in childcare, aged care, and hospitality with the tools to maintain a safe environment and protect against foodborne illnesses.

Despite the warnings, consumers continue to wash raw chicken before cooking
It’s one of the most dangerous cooking practices. An American study found 60% of consumers had bacteria in their sink after washing poultry, and 26% had cross-contamination and 14% still had high levels of bacteria in their sinks after they were cleaned.
Take Steps to Prevent the No.1 Cause of Food Poisoning
Don't wait until it's too late. Download 'Bacterial Contamination Kills' now and equip yourself with essential knowledge to protect against dangerous and deadly foodborne diseases.
Get Your Free Download Now